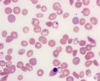
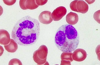
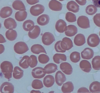
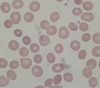
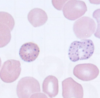
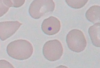
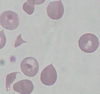
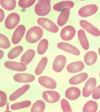
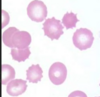
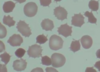

Risk a child will be a carrier of beta-thalassaemia trait if both parents are carriers?
50%
Risk a child will have beta-thalassaemia trait if both parents are carriers?
25%
Risk a child will be unaffected if both parents are carriers beta-thalassaemia trait?
25%
Macrocytosis, anaemia, and hypersegmented polymorphonuclear cells on blood film, peripheral neuropathy and glossitis
Pernicious anaemia
Abnormally large and oval-shaped RBCs
Pernicious anaemia
Normochromic-normocytic haemolytic disorder
Sickle cell anaemia
Microcytic and hypochromic anaemia. High transferrin, ferritin and serum iron is low
Iron deficiency anaemia
Hypochromic, microcytic red cells
Additional pencil cells
Occasional target cells
Iron deficiency anaemia
Heinz bodies (denatured haemoglobin secondary to oxidative damage) and bite cells (erythrocytes with an irregular membrane caused by splenic macrophages attempting to remove Heinz bodies)
G6PD
Acute kidney injury, microangiopathic haemolytic anaemia and thrombocytopenia
Escherichia coli
A negative Coombs test indicates…
Non-immune cause of haemolytic anaemia
Macrocytosis and anaemia
Vitamin B12 or folate deficiency, or rarely, pernicious anaemia
Reticulocytosis and macrocytosis but haemoglobin levels are usually normal or increased
Haemolytic anaemia
Non-megaloblastic macrocytic anaemia
Hypothyroidism
High total iron binding capacity (TIBC) with low ferritin
Iron deficiency anaemia
Pancytopenia along with hypocellular bone marrow and absence of haematopoietic cells
Aplastic anaemia
Antiphospholipid syndrome triad
Venous and arterial thromboses, recurrent fetal loss and thrombocytopenia
Mx for APS in pregnancy
Aspirin once pregnancy confirms on urine test
LMWH once fetal heart seen on US until 34 weeks
Most common inherited bleeding disorder?
Von Willebrand’s disease
How is VWD inherited?
Autosomal dominant
VWD behaves like a..
Platelet disorder i.e. epistaxis and menorrhagia are common whilst haemoarthroses and muscle haematomas are rare
3 roles of VWF
Large glycoprotein which forms massive multimers up to 1,000,000 Da in size
Promotes platelet adhesion to damaged endothelium
Carrier molecule for factor VIII
3 types of VWF
1: partial reduction in vWF (80% of patients)
2: abnormal form of vWF
3: total lack of vWF (autosomal recessive)
Defective platelet aggregation with ristocetin
VWF